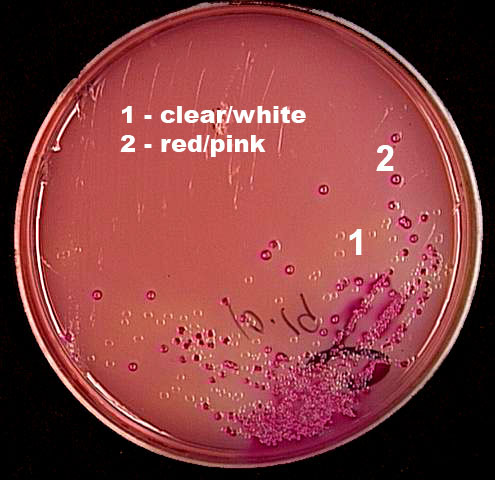

![]()
Created by
Paul A. Gulig, Ph.D.
Department of Molecular Genetics and Microbiology
with assistance from
David Brumbaugh
Here is the result of the MacConkey agar plate from the case.
There are two colony types visible on this plate. There are three
colonies of type 1 around the number 1, and they are colorless. The number
2 is in between two colonies that are red in color.
There are two colony types visible on this plate. There are three
colonies of type 1 around the number 1, and they are colorless. The number
2 is in between two colonies that are red in color.
What is the significance of the two colony types?
A. Type 1 is lactose-positive, and type 2 is
lactose-negative.
B. Type 2 is lactose-positive, and type 1 is
lactose-negative.
C. Type 1 is gram-positive, and type 2 is
gram-negative.
D. Type 2 is gram-positive, and type 1 is
gram-negative.
Click here to see a Gram stain of colonies 1 and 2.
What is the next test to do with colony type 2?
A. Catalase test
B. Coagulase test
C. Citrate test
D. Antibiotic resistance